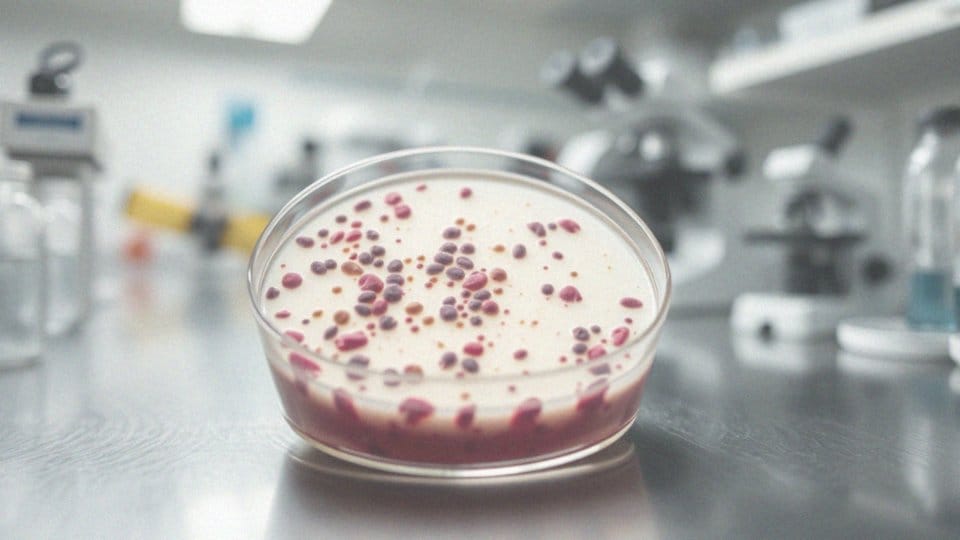

Spis treści
Jakie są podstawowe informacje o wirusach i bakteriach?
Wirusy to niewielkie cząsteczki zakaźne, które nie mają budowy komórkowej. Ich wielkość waha się od 20 do 300 nanometrów. Nie są w stanie rozmnażać się samodzielnie; do tego procesu potrzebują komórek gospodarza. Z kolei bakterie to jednokomórkowe organizmy prokariotyczne, które mają od 0,2 do 10 mikrometrów średnicy. Rozmnażają się poprzez podział komórkowy, co umożliwia im błyskawiczny wzrost liczebności.
W biologii, szczególnie w piątej klasie, uczniowie poznają klasyfikację wirusów i bakterii oraz ich rolę w życiu ludzi i ekosystemów. Na przykład:
- wirusy mogą powodować różnorodne choroby, takie jak grypa czy COVID-19,
- bakterie natomiast mogą być zarówno pożyteczne, jak i szkodliwe,
- niektóre z nich są odpowiedzialne za infekcje, takie jak zapalenie płuc czy angina.
Wirusy i bakterie odgrywają kluczową rolę w biologii oraz w naszym codziennym życiu. Wiedza na ich temat jest istotna dla ochrony zdrowia oraz zrozumienia różnych procedur medycznych. Podczas lekcji uczniowie mają okazję prowadzić obserwacje pod mikroskopem, co pozwala im lepiej zgłębić strukturę i funkcje tych mikroorganizmów.
Co uczą się uczniowie klasy 5 o wirusach i bakteriach?
Podczas zajęć z biologii uczniowie piątej klasy odkrywają istotne informacje dotyczące wirusów i bakterii. Zwracają uwagę na ich cechy oraz wpływ na zdrowie człowieka. Dowiadują się, że oba te mikroorganizmy mogą być przyczyną różnych chorób, mimo że różnią się zarówno wyglądem, jak i sposobem działania. Na przykład, wirusy odpowiadają za takie infekcje jak:
- grypa,
- COVID-19,
- przeziębienie.
Z drugiej strony, niektóre bakterie, takie jak te wywołujące:
- zapalenie płuc,
- anginę,
- również mogą stanowić zagrożenie.
Warto jednak zaznaczyć, że istnieją też bakterie jelitowe, które są korzystne dla naszego organizmu, ponieważ wspierają procesy trawienne. Podczas lekcji uczniowie szczegółowo omawiają, w jaki sposób wirusy i bakterie się rozprzestrzeniają. Uczą się, że wirusy często przenoszą się drogą kropelkową, kiedy osoby zakażone kaszlą lub wydychają powietrze. Z kolei bakterie mogą być przekazywane poprzez bezpośredni kontakt z zarażonymi ludźmi lub przez spożycie zanieczyszczonej żywności i wody. Uczniowie mają również okazję poznać funkcje bakterii w przyrodzie — są one niezbędne w ekosystemach, pełniąc szereg ról, takich jak:
- rozkład materii organicznej,
- wspieranie procesów biodegradacji.
Wiedza na temat wirusów i bakterii jest niezwykle ważna, aby lepiej zrozumieć zasady zdrowego stylu życia oraz profilaktyki chorób, co podkreśla ich kluczowe znaczenie w edukacji biologicznej w szkole podstawowej.
Jakie są różnice między wirusami a bakteriami?
Wirusy i bakterie, choć często mylone, różnią się nie tylko budową, ale również mechanizmami działania. Wirusy to mikroskopijne cząstki zakaźne, które nie posiadają komórek; ich klasyfikacja zależy głównie od rodzaju materiału genetycznego, którym mogą być DNA lub RNA. Natomiast bakterie to jednokomórkowe organizmy prokariotyczne, które charakteryzują się obecnością ściany oraz błony komórkowej.
W przeciwieństwie do wirusów, które wymagają komórek gospodarza do reprodukcji, bakterie mają zdolność do samodzielnego rozmnażania się poprzez podział. Warto również zauważyć, że antybiotyki są skuteczne jedynie w walce z bakteriami, co oznacza, że infekcje wirusowe wymagają odmiennych metod leczenia. Dodatkowo, wirusy mogą prowadzić do poważnych chorób, podczas gdy niektóre bakterie mogą być wręcz korzystne dla zdrowia człowieka.
Dlatego uczniowie powinni zwrócić szczególną uwagę na te istotne różnice, które są kluczowe dla pełniejszego zrozumienia zagadnień związanych ze zdrowiem i chorobami.
Co powodują wirusy i jakie choroby wywołują?

Wirusy są odpowiedzialne za szereg schorzeń, które negatywnie oddziałują na zdrowie ludzi, zwierząt oraz roślin. Wśród znanych chorób wirusowych można wymienić:
- grypę,
- ospę wietrzną,
- odrę,
- różyczkę,
- świnkę,
- AIDS,
- COVID-19.
Te mikroorganizmy wnikają do komórek gospodarza, gdzie się namnażają, co prowadzi do ich uszkodzenia oraz wystąpienia charakterystycznych symptomów. Wirusy rozprzestrzeniają się głównie drogą kropelkową, co oznacza, że mogą przenosić się z osoby na osobę przez kaszel, kichanie czy kontakt z zakażonymi powierzchniami. Wydarzenia związane z pandemią COVID-19 szczególnie uwydoczniły wpływ wirusów na zdrowie publiczne na całym świecie.
Objawy chorób wirusowych mogą być zróżnicowane – często obejmują:
- gorączkę,
- ból mięśni,
- kaszel.
A w niektórych przypadkach dochodzi do poważnych komplikacji jak:
- zapalenie płuc,
- niewydolność organów.
Leczenie zazwyczaj koncentruje się na łagodzeniu tych objawów, ale są też wirusy, dla których dostępne są szczepionki, na przykład wirus grypy. Przyjmowanie takich szczepionek pomaga ograniczać rozprzestrzenianie się wirusa. Należy pamiętać, że wirusy nie potrafią samodzielnie metabolizować ani się reprodukować – ich obecność zawsze niesie ze sobą zagrożenie, dlatego ważne jest stosowanie odpowiednich metod profilaktycznych oraz leczenia.
Jakie choroby bakteryjne mają znaczenie dla zdrowia?
Choroby wywołane przez bakterie stanowią istotny problem zdrowotny w naszej społeczności. Do najczęstszych należy:
- salmonelloza, która często wynika ze spożycia żywności zanieczyszczonej tymi patogenami,
- tężec, zazwyczaj będący efektem zranień, które uległy infekcji,
- borelioza, przenoszona za pośrednictwem kleszczy,
- gruźlica, rozprzestrzeniająca się drogą kropelkową od nosicieli bakterii,
- angina, powstająca na skutek zakażeń wywołanych przez paciorkowce,
- zapalenie płuc, groźna choroba bakteryjna często wymagająca hospitalizacji, wywoływana przez takie bakterie jak Streptococcus pneumoniae oraz Haemophilus influenzae.
Wprowadzenie zasad higieny, takich jak systematyczne mycie rąk, unikanie kontaktu z osobami chorymi oraz odpowiednie przechowywanie żywności, może znacznie zmniejszyć ryzyko infekcji. Dodatkowo, obecność nosicieli bezobjawowych sprawia, że sytuacja epidemiologiczna staje się bardziej skomplikowana. Dzięki edukacji na temat tych chorób i profilaktyce zdrowotnej mamy szansę skutecznie je kontrolować.
Jakie są cechy bakterii?
Bakterie to mikroskopijne organizmy jednokomórkowe, charakteryzujące się prostą budową komórkową oraz brakiem jądra. Ich materiał genetyczny składa się z pojedynczej nici DNA. Ściana komórkowa tych mikroorganizmów ma różne formy, co nie tylko chroni je przed szkodliwymi wpływami zewnętrznymi, ale również pozwala na interakcję z otoczeniem.
Bakterie występują w różnych kształtach – mogą być:
- kuliste,
- podłużne,
- spiralne.
Ta różnorodność umożliwia im przystosowanie do rozmaitych środowisk, co jest kluczowe dla ich przetrwania. Niektóre z nich potrafią egzystować w skrajnych warunkach, takich jak wysokie temperatury czy znaczne stężenia soli, a także w miejscach, gdzie brakuje tlenu. Spotykamy je praktycznie wszędzie: w glebie, wodzie oraz na organizmach żywych, w tym także na ludzkim ciele.
Choć wiele bakterii pełni pozytywną rolę, wspierając procesy trawienne w jelitach, inne mogą wywoływać różnorodne choroby. Ich cechy sprawiają, że są niezwykle istotne dla funkcjonowania ekosystemów – biorą udział w obiegu materii oraz rozkładzie substancji organicznych, co ma bezpośredni wpływ na zdrowie naszej planety. Dodatkowo, obecność bakterii jest kluczowa dla wielu procesów biologicznych zachodzących w środowisku.
Jakie kształty mają bakterie?
Bakterie występują w bardzo zróżnicowanych kształtach, co odgrywa kluczową rolę w ich klasyfikacji. Najczęściej spotykane są formy:
- kuliste,
- cylindryczne,
- spiralne.
Kuliste bakterie, takie jak paciorkowce czy gronkowce, charakteryzują się sferyczną symetrią, co znacznie ułatwia im rozprzestrzenianie się w różnych środowiskach. Z kolei cylindryczne bakterie, popularnie nazywane pałeczkami, mają wydłużony kształt, co sprzyja ich kolonizacji na wielu powierzchniach. Spiralne bakterie, jak krętki, przybierają skręcony kształt, co umożliwia im swobodne poruszanie się w cieczy. Ta różnorodność kształtów ma istotny wpływ na zdolność bakterii do adaptacji w zmieniających się warunkach środowiskowych, a to z kolei jest niezbędne dla ich przetrwania.
W piątej klasie biologii uczniowie odkrywają, jak różne kształty bakterii wpływają na ich funkcje w ekosystemie i jakie mają znaczenie dla zdrowia ludzi. Na przykład, spiralny kształt może ułatwiać bakteriom wnikanie w tkanki roślinne lub zwierzęce, co ma bezpośrednie konsekwencje dla interakcji tych organizmów z ich otoczeniem.
Gdzie mogą żyć bakterie?
Bakterie to niezwykle różnorodne organizmy, zdolne do życia w najrozmaitszych warunkach. Spotkać je można zarówno w:
- glebie,
- wodzie,
- powietrzu,
- a nawet w ciałach innych stworzeń.
Część z nich zasiedla zewnętrzne powierzchnie, takie jak skóra czy jelita, podczas gdy inne żyją wewnątrz organizmów. Co więcej, te mikroby potrafią przetrwać w ekstremalnych warunkach, takich jak:
- wysoka temperatura,
- silne kwasy,
- całkowity brak tlenu.
Na przykład, bakterie termofilne rozwijają się w gorących źródłach, a halofilne zamieszkują solone wody. Ich obecność jest nieoceniona w ekosystemach, ponieważ aktywnie uczestniczą w procesach rozkładu materii organicznej, co korzystnie wpływa na zdrowie środowiska. Zdolność tych organizmów do adaptacji w trudnych warunkach podkreśla ich znaczenie w naturze, zarówno w kontekście ekosystemów, jak i wpływu na życie ludzi. Bakterie zdobywają pożywienie z różnych substancji organicznych, co sprawia, że ich rozwój jest niezwykle zróżnicowany.
Jak bakterie się odżywiają?
Bakterie odżywiają się na różne sposoby, co jest związane z ich klasyfikacją. Wiele z nich to organizmy cudzożywne, które zdobywają pokarm z otaczającej je materii organicznej. Można je zgrupować w dwóch głównych kategoriach:
- bakterie saprofityczne, które rozkładają martwe substancje,
- bakterie pasożytnicze, żyjące kosztem innych organizmów.
Te mikroorganizmy pozyskują energię na dwa główne sposoby:
- poprzez oddychanie tlenowe, w którym bakterie wykorzystują tlen do przekształcania substancji organicznych w energię,
- oraz fermentację, która zachodzi w środowisku beztlenowym, co jest istotne dla tych bakterii, które bytują w ubogich w tlen warunkach.
Na przykład, w jelitach człowieka bakterie odgrywają niezwykle ważną rolę w trawieniu, przetwarzając resztki pokarmowe i wytwarzając niezbędne witaminy. Różnorodność strategii żywieniowych tych mikroorganizmów podkreśla ich ogromne znaczenie dla ekosystemów oraz wpływ na zdrowie człowieka. Mimo że niektóre bakterie mogą być patogenne, wiele z nich przyczynia się do naszego zdrowia, biorąc udział w biodegradacji oraz obiegu materii w naturze.
W jaki sposób rozmnażają się bakterie?
Bakterie rozmnażają się głównie poprzez podział komórkowy, co jest formą bezpłciowego rozmnażania. W tym procesie jedna pojedyncza komórka dzieli się na dwie identyczne komórki córki, co sprawia, że jest to niezwykle skuteczna metoda. Dzięki niej, w sprzyjających warunkach, bakterie potrafią błyskawicznie zwiększać swoją liczebność.
W optymalnych warunkach, takich jak:
- odpowiednia temperatura,
- obfitość pożywienia,
- niektóre gatunki mają zdolność do rozmnażania się co 20 minut,
- co prowadzi do gwałtownego wzrostu ich populacji.
Rozmnażanie bakterii jest kluczowe dla ich przetrwania oraz adaptacji do różnorodnych środowisk. Co więcej, mogą one wymieniać materiał genetyczny, na przykład poprzez koniugację, co z kolei zwiększa ich różnorodność genetyczną i zdolność do przetrwania w zmieniających się warunkach.
Procesy te mają ogromne znaczenie nie tylko dla samego życia bakterii, ale także dla zdrowia ludzi oraz funkcjonowania ekosystemów, w których zachodzi obieg materii organicznej. Zrozumienie mechanizmów rozmnażania bakterii jest zatem istotne w biologii i medycynie. Warto zauważyć, że intensywne namnażanie tych mikroorganizmów może prowadzić do pojawienia się patogennych szczepów, które są odpowiedzialne za różne choroby.
Jakie są drogi rozprzestrzeniania się bakterii?

Bakterie mają różne sposoby rozprzestrzeniania się, co ma istotny wpływ na ich ekologię oraz nasze zdrowie. Przykładowo, jednym z głównych mechanizmów przenoszenia jest d droga kropelkowa. Kiedy ktoś kaszle lub kicha, wydobywają się małe krople z patogenami, które mogą być wchłonięte przez osoby znajdujące się w pobliżu, co często prowadzi do infekcji dróg oddechowych.
Kolejnym istotnym sposobem jest d droga pokarmowa, podczas której osobnik może się zarazić przez spożycie zanieczyszczonej żywności lub wody. Na przykład, bakterie takie jak Salmonella są odpowiedzialne za poważne infekcje, często spowodowane niewłaściwym przechowywaniem produktów spożywczych.
Nie można zapominać o drodze płciowej; bakterie mogą przenosić się również wskutek kontaktów seksualnych. Do chorób, które należy wymienić w tym kontekście, należą chlamydia oraz rzeżączka.
Ostatnim, ale równie ważnym sposobem jest kontakt bezpośredni. Zakażone osoby bądź przedmioty mogą być źródłem infekcji. Przykładowo, dotykając powierzchni, na których znajdują się patogeny, a następnie dotykając twarzy, narażamy się na przejęcie bakterii.
Zrozumienie tych różnych dróg rozprzestrzeniania się bakterii jest kluczowe w kontekście profilaktyki zdrowotnej. Regularne dbanie o higienę oraz prowadzenie zdrowego stylu życia może znacząco wpłynąć na ochronę przed potencjalnymi zakażeniami.
Jak wirusy się rozprzestrzeniają?
Wirusy rozprzestrzeniają się na wiele sposobów, co ma kluczowe znaczenie dla zrozumienia ich wpływu na nasze zdrowie. Do podstawowych metod przenoszenia należy zaliczyć:
- bezpośredni kontakt z osobą zakażoną,
- drogę kropelkową,
- kontakt z zanieczyszczonymi powierzchniami.
Droga kropelkowa, stanowiąca jedną z najpowszechniejszych form transmisji, polega na tym, że kiedy zarażona osoba kaszle, kicha lub rozmawia, uwalnia małe krople zawierające wirusy. Te drobinki łatwo mogą trafić do dróg oddechowych osób znajdujących się blisko, co prowadzi do zakażeń, przykładem może być wirus grypy. Dodatkowo, wirusy mogą przenikać przez zanieczyszczone powierzchnie; dotykając ich, można narazić się na przeniesienie wirusa do ust lub nosa, co znacząco zwiększa ryzyko zakażenia.
Istnieje również możliwość przenoszenia wirusów drogą powietrzną, zwłaszcza w zamkniętych pomieszczeniach, gdzie mogą one unosić się przez dłuższy czas. Każdy wirus ma swoje unikalne sposoby zakażania i rozprzestrzeniania się, co sprawia, że skuteczna profilaktyka wymaga zrozumienia tych różnic. Stosowanie właściwych metod ochrony zdrowia, takich jak:
- higiena rąk,
- używanie masek ochronnych,
- unikanie bliskiego kontaktu z osobami chorymi,
może znacząco zredukować ryzyko wystąpienia infekcji wirusowych.
Jakie jest znaczenie bakterii w przyrodzie?
Bakterie odgrywają niezwykle istotną rolę w świecie przyrody. Angażują się w szereg kluczowych procesów ekologicznych, które są fundamentem zdrowych ekosystemów. Ich obecność jest niezbędna do rozkładu materii organicznej, co pozwala na utrzymanie harmonii w środowisku.
Co więcej, mikroorganizmy te są zaangażowane w obieg ważnych pierwiastków, takich jak:
- azot,
- węgiel.
Na przykład, bakterie brodawkowe mają unikalną zdolność wiązania azotu z atmosfery, co jest niezwykle ważne dla wzrostu roślinności. Dodatkowo, poprzez fermentację, bakterie przyczyniają się do produkcji cennych substancji, w tym probiotyków, które są korzystne dla zdrowia jelit.
Ich obecność w glebie jest kluczowa dla procesu tworzenia humusu, co z kolei ma znaczący wpływ na jakość gleby oraz jej zdolność do zatrzymywania wody. Można je znaleźć w wielu różnych środowiskach – od gleby, przez wodę, aż po organizmy żywe, co świadczy o ich niesamowitej zdolności do adaptacji w skrajnych warunkach.
Wpływ bakterii na zdrowie zarówno naszej planety, jak i samych ludzi jest niezastąpiony. Wspierają one szereg procesów biologicznych, które są kluczowe dla prawidłowego funkcjonowania wszelkich organizmów.
Dlaczego bakterie są ważne dla człowieka?
Bakterie pełnią niezwykle ważną rolę w naszym życiu i mają znaczenie w wielu sektorach przemysłu. Uczestniczą w kluczowych procesach biologicznych i wiele z nich jest niezbędnych dla naszego zdrowia.
Weźmy na przykład mikroflorę jelitową, która wspiera trawienie i produkuje witaminy, takie jak:
- witamina K,
- niektóre z grupy B.
W branży spożywczej bakterie są wykorzystywane do produkcji:
- jogurtów,
- serów,
- kiszonek,
- fermentowanych napojów,
co wpływa na ich smak, konsystencję i trwałość. Bakterie probiotyczne szczególnie zasługują na uwagę, ponieważ wspomagają układ odpornościowy i poprawiają funkcjonowanie układu pokarmowego, dlatego warto, abyśmy uwzględniali je w naszej diecie.
W medycynie bakterie odegrały rewolucyjną rolę w produkcji antybiotyków. Dzięki nim, takim jak penicylina, możliwe stało się skuteczne leczenie wielu chorób bakteryjnych, ratując życie milionów ludzi.
W środowisku naturalnym mikroorganizmy uczestniczą w istotnych procesach ekologicznych, na przykład przy rozkładzie materii organicznej, co wpływa na odnowę gleb i cykl pierwiastków. Z tego względu bakterie stanowią fundamentalny element ekosystemów i mają kluczowe znaczenie dla zdrowia człowieka.
Ich znaczenie dla codziennego życia oraz zrównoważonego rozwoju naszej planety jest nie do przecenienia.
Jakie są pozytywne i negatywne znaczenia bakterii?
Bakterie mają dwa zasadnicze oblicza: mogą być zarówno korzystne, jak i szkodliwe. Pozytywne aspekty ich obecności tkwią głównie w ich rolach w ekosystemach. Rozkładając materię organiczną, przyczyniają się do obiegu pierwiastków i powstawania gleby, co z kolei zwiększa jej żyzność oraz wspiera rozwój roślin. Szczególnie istotne są w produkcji żywności, na przykład w wytwarzaniu jogurtów czy serów. Dodatkowo, bakterie są nieocenione w medycynie, przede wszystkim podczas produkcji leków i antybiotyków.
Z drugiej strony, nie można zignorować ich negatywnego wpływu. Wiele bakterii jest odpowiedzialnych za groźne choroby, takie jak:
- salmonelloza,
- gruźlica,
- angina.
Co stanowi poważne zagrożenie dla zdrowia ludzi, zwierząt oraz roślin. Oprócz tego, zbyt duża ich ilość w żywności może prowadzić do jej psucia, co wiąże się z istotnymi stratami ekonomicznymi. Dlatego w ramach edukacji biologicznej kluczowe jest rozróżnianie pomiędzy pożytecznymi a szkodliwymi bakteriami. Znajomość ich znaczenia pozwala lepiej zrozumieć ich wpływ na zdrowie człowieka oraz kondycję ekosystemów, co może przyczynić się do efektywnej ochrony i wykorzystania tych mikroorganizmów w naszej codzienności.